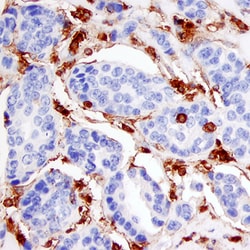
Human/Mouse Annexin A1 Antibody, R D Systems 25&mu;g; Unlabeled:Antibodies,

missing translation for 'onlineSavingsMsg'
Learn More
Learn More
Human/Mouse Annexin A1 Antibody, R&D Systems™


Mouse Monoclonal Antibody
Brand: R&D Systems MAB3770-SP
This item is not returnable.
View return policy
Description
Annexin A1 Monoclonal specifically detects Annexin A1 in Human, Mouse samples. It is validated for Immunohistochemistry, Immunocytochemistry, Knockout Validated.
Specifications
| Annexin A1 | |
| Monoclonal | |
| LYOPH | |
| Immunohistochemistry 8-25 ug/mL, Immunocytochemistry 3-25 ug/mL, Knockout Validated | |
| P04083 | |
| ANXA1 | |
| E. coli-derived recombinant human Annexin A1 Met1-Asn346 Accession # P04083 | |
| 25 μg | |
| Primary | |
| Detects human Annexin A1 in direct ELISAs. Detects human and mouse Annexin A1 in Western blots. In direct ELISAs, no cross-reactivity with recombinant human Annexin A2, A3, A4, A6, A7, A8, A9, A10, A11, or A13 is observed. | |
| Human, Mouse | |
| Purified |
| Immunohistochemistry, Immunocytochemistry, Immunoassay | |
| 686106 | |
| Unconjugated | |
| Lyophilized from a 0.2 μm filtered solution in PBS with Trehalose. *Small pack size (SP) is supplied as a 0.2 μm filtered solution in PBS. with No Preservative | |
| annexin A1, Annexin I, annexin I (lipocortin I), Annexin-1, ANX1, ANXA1, Calpactin II, calpactin-2, Chromobindin-9, Lipocortin I, LPC1, LPC1annexin-1, p35, Phospholipase A2 inhibitory protein | |
| Mouse | |
| Protein A or G purified from hybridoma culture supernatant | |
| RUO | |
| 301 | |
| Sterile PBS to a final concentration of 0.5 mg/mL. | |
| Use a manual defrost freezer and avoid repeated freeze-thaw cycles. 12 months from date of receipt, -20 to -70 degreesC as supplied. 1 month, 2 to 8 degreesC under sterile conditions after reconstitution. 6 months, -20 to -70 degreesC under sterile conditions after reconstitution. | |
| IgG1 |
Product Content Correction
Your input is important to us. Please complete this form to provide feedback related to the content on this product.
Product Title
For Research Use Only
Spot an opportunity for improvement?Share a Content Correction